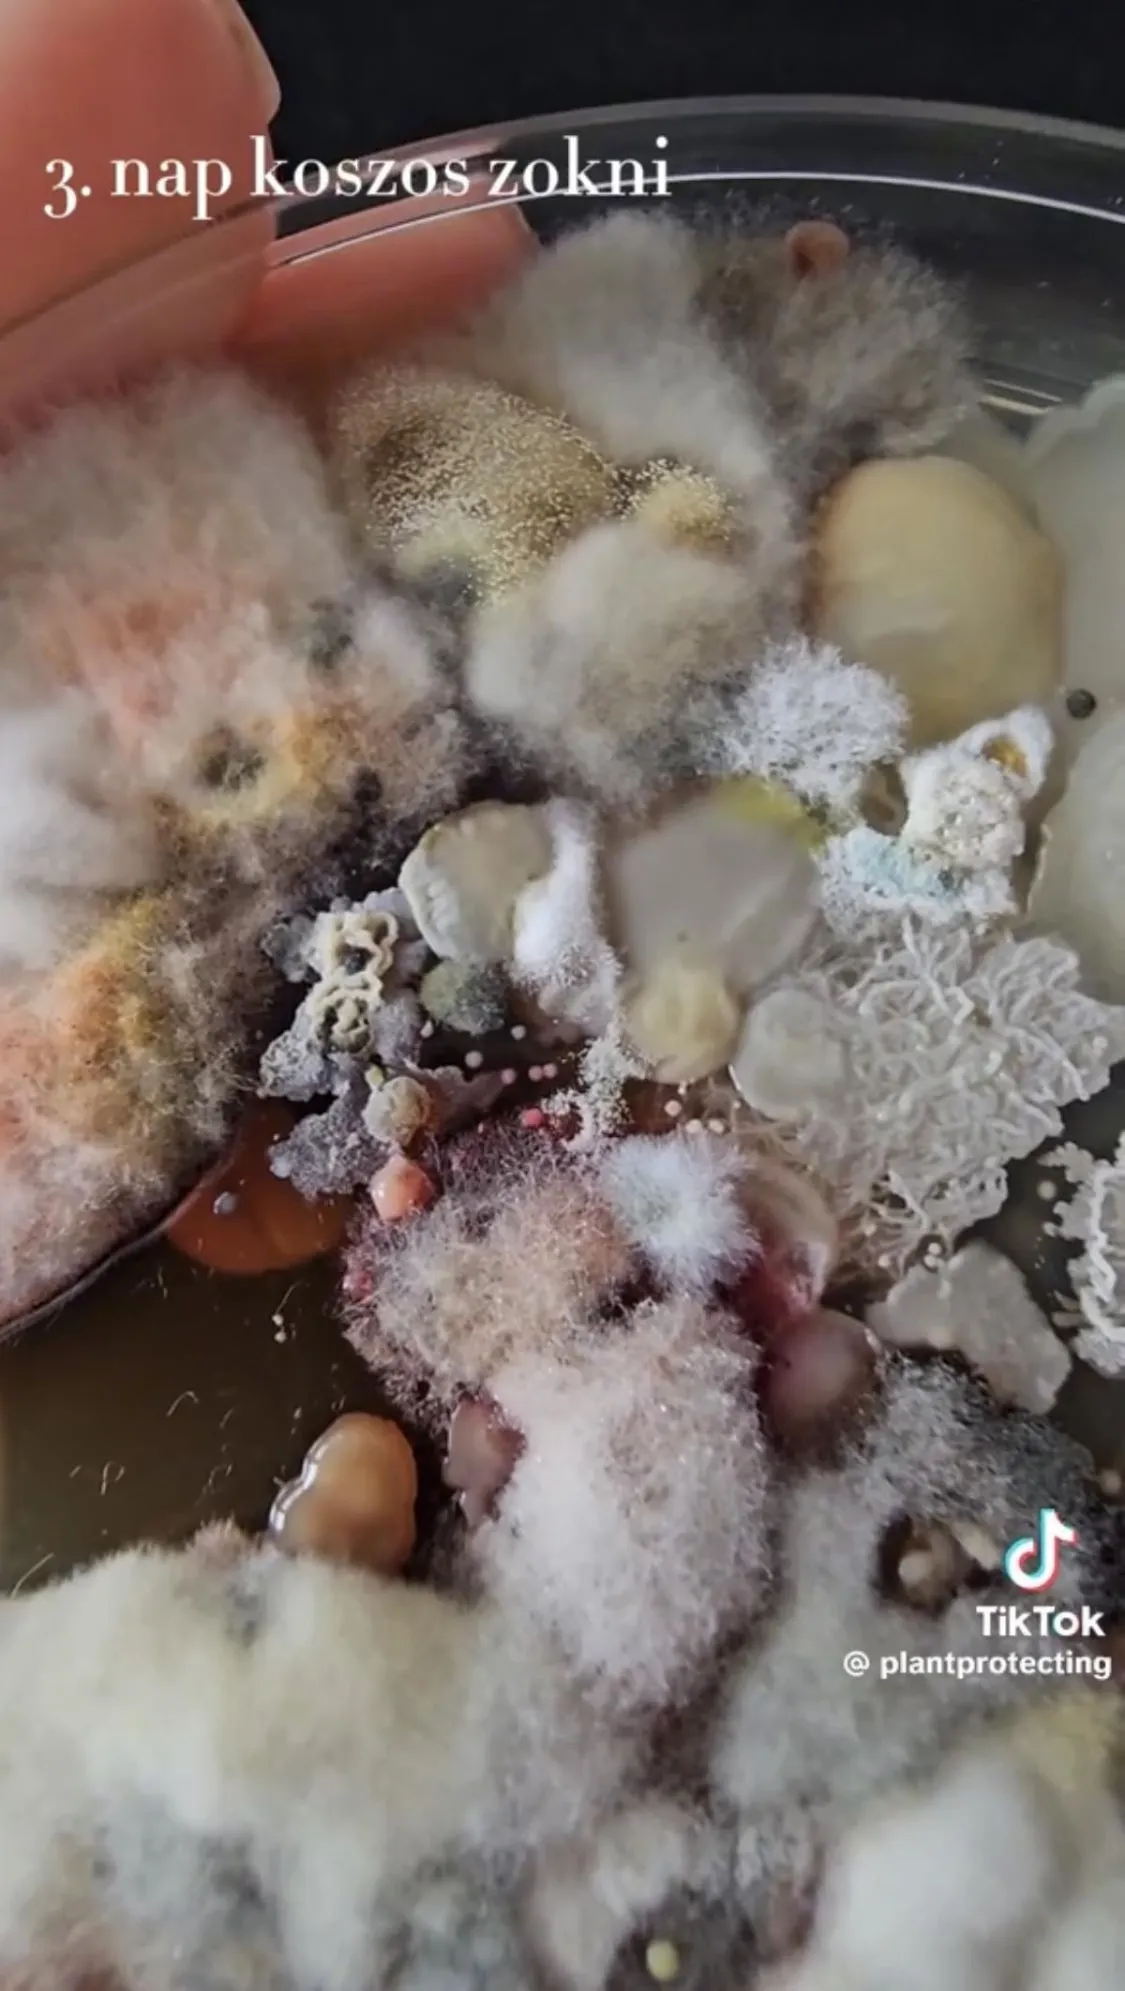

Ha ezt a videót megnézed, soha többé nem veszel fel piszkos zoknit
Rita, a növényorvos összehasonlította, hogy mennyi gomba és baktériumtelep van a tiszta és az egy napig hordott zoknin. Az eredmény megdöbbentő.
Gyuris Rita, a TikTok kedvenc növényorvosa egy újabb bizarr kísérlettel rukkolt elő. Megmutatta, hogy egy hosszú nap végén mennyi gomba és baktériumtelep található a használt zoknin. Ezt hasonlította össze egy kimosott párral.

„Nézzük meg, mennyi mikroorganizmus van egy tisztán felvett zoknin, illetve egy egynapos zoknin!” – kezdte TikTok-videójában a növényorvos.
A tiszta zoknit fölvettem és hozzáérintettem a táptalajhoz, mielőtt letettem volna a lábam a földre
– folytatta. Rita egész nap otthon mászkált a zoknijában, majd a nap végén mintát vett róla.

Íme az eredmény:
A tiszta zokniról vett mintán már az első napon számos baktériumkolónia nőtt fel; a koszos zokninál is hasonló volt a helyzet, azonban itt sokkal gyorsabban szaporodtak, tehát növekedtek a táptalajon az élőlények.
Az idő előrehaladtával egyre több baktérium és gomba ütötte fel a fejét
– mondta a növényorvos.
„Tiszta zokniban lévő baktériumok és gombák a hatvan fokos mosás hatására sem pusztultak el”
A koszos zoknin sokkal többféle mikroorganizmus él, tehát mindenképp érdemes este betenni a szennyesbe. A tiszta zokniban lévő baktériumok és gombák a hatvan fokos mosás hatására sem pusztultak el
– állapította meg a szakember, aki próbált megnyugtatni minket: „Ez normális, nem kell sterilen élnünk. A mikroorganizmusok és csírák csak kis mennyiségben vannak jelen és speciális táptalaj kell, ahhoz, hogy fel tudjanak szaporodni. Én csak azt mutatom meg, ami a szemnek láthatatlan. A mikroorganizmusok az életünk részei és nagyon fontos szerepük van az életben. Vannak közöttük jó baktériumok és gombák és vannak közöttük rossz baktériumok és gombák, ezeket nevezzük kórokozóknak; de a kórokozók közül sem kell mindegyiktől félni, ugyanis nem biztos, hogy humán patogének, tehát nem biztos, hogy képesek megbetegíteni az embert.”








